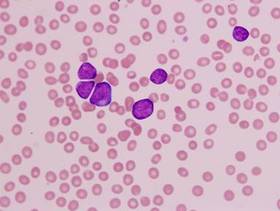

Bloomington Native Isaiah Newkirk Presents "Blood Through a Lens" at Marian University
Senior art project raises provocative questions about medical ethics
Related Media
INDIANAPOLIS, IN (12/07/2011)(readMedia)-- Marian University senior photography and fine arts major Isaiah Newkirk combined the disciplines of art and science to create distinctively beautiful and provocative images of human cells. Inspired by the book The Immortal Life of Henrietta Lacks, Newkirk's images are intended to remind us of the humanity that exists in samples of human tissue intended for scientific research.
The cells used in Newkirk's photography are from a leukemia patient. "Once I was told that the individual's blood that I was photographing may be suffering from cancer, I realized how easy it was just to see them as an objective, and not actually see the patient as someone to care for but instead just a puzzle to solve," said Newkirk.
Henrietta Lacks was a poor farmer whose cells were taken without her knowledge and subsequently cultured for use in medical research. The culture, known as HeLa cells, were used by Dr. Jonas Salk to develop the polio vaccine. The moral and ethical dilemma posed by the handling of her samples contributed directly to Newkirk's project.
His work and that of other senior art students will be on display in the Fisher Hall Art Gallery through December 16, 2011.